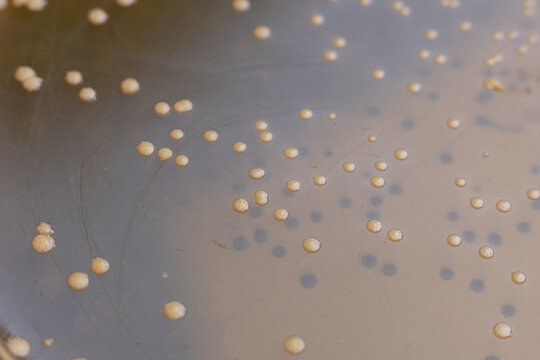
Salmonellosis Bilder Durchsuchen 1,358 Archivfotos,

Con il termine zoonosi si intende una qualsiasi malattia infettiva che può essere trasmessa dagli animali (escluso l'uomo) all'uomo (se la trasmissione avviene dall'uomo ad altre specie animali, si parla di antroponosi) direttamente (contatto con la pelle, peli, uova, sangue o secrezioni) o indirettamente (tramite altri organismi vettori o ingestione di alimenti infetti).
Il termine zoonosi è onnicomprensivo, ma ne esistono altri, usati a volte in sinonimia, aventi significato più esplicativo: antropozoonosi indica malattie trasmesse all’uomo dagli altri vertebrati mentre zooantroponosi indica malattie trasmesse agli altri vertebrati dall’uomo. Con anfixenosi si indicano, infine, malattie presenti sia nell’uomo sia negli altri vertebrati e reciprocamente trasmissibili.
La salute umana è correlata strettamente a quella degli animali con cui l'uomo entra in contatto o di cui l'uomo si serve. Le zoonosi pertanto conferiscono carattere di pericolosità a molte attività che richiedono contatti con gli animali. Rappresentano pertanto una continua fonte di pericolo e sono oggetto di ricerche da parte di ricercatori che sono pervenuti a riconoscerne più di un centinaio (ad esempio, virosi, rickettsiosi, micosi, malattie protozoarie, elmintiasi, infestazioni trasmesse da artropodi e da insetti).
Le zoonosi trasmissibili attraverso gli alimenti possono inoltre essere fonte di gravi perdite economiche per l'industria degli alimenti, in quanto quando si manifesta un focolaio di infezione, gli alimenti infetti o sospetti infetti devono essere distrutti. Costituiscono fonte di preoccupazione anche le zoonosi trasmesse da fonti diverse dagli alimenti, in particolare quelle trasmesse dagli animali selvatici e dagli animali da compagnia.
Sviluppo storico delle malattie zoonotiche
Durante la preistoria le persone erano generalmente organizzate in piccoli gruppi di cacciatori-raccoglitori, che molto raramente erano costituiti da più di 150 individui e che non entravano sovente in contatto con altri gruppi. Per questa ragione le malattie epidemiche o pandemiche che dipendono dal costante afflusso ed efflusso di nuovi esseri umani che non hanno sviluppato una risposta immune tendevano ad esaurirsi (anche perché scontavano una naturale quarantena) in una popolazione.
Per sopravvivere, un patogeno biologico deve provocare un'infezione cronica, i germi devono rimanere vitali nell'ospite a lungo o avere comunque un reservoir non umano (vettore) nel quale vivere e proliferare mentre si attende un nuovo ospite. In effetti, per molte delle malattie 'umane' l'essere umano è spesso una vittima accidentale ed un ospite a vicolo-cieco. È il caso della rabbia, dell'antrace, della tularemia, del virus del Nilo occidentale e molte altre. Questo fattore ha influito sullo sviluppo umano in relazione a malattie zoonotiche non epidemiche.
Molte malattie moderne, anche epidemiche, sono iniziate come zoonosi, ovvero l'agente patogeno ha subito una modificazione (in gergo scientifico salto di specie) che gli ha permesso di vivere e moltiplicarsi non solo nell'animale, ma anche nell'organismo umano. È difficile avere la certezza su quali malattie sono passate dagli animali all'uomo, ma ci sono prove evidenti che il morbillo, il vaiolo, l'influenza e la difterite sono pervenute all'uomo con tale modalità. Anche l'HIV, il comune raffreddore e la tubercolosi potrebbero provenire dagli animali. Attualmente le zoonosi sono di interesse pratico perché spesso si tratta di malattie non diagnosticate e perché oggi esse hanno maggior virulenza a causa delle basse difese immunitarie delle popolazioni. Il virus del Nilo occidentale apparve negli USA nel 1999 nell'area di New York ed attraversò il paese nell'estate del 2002, causando molti problemi. La peste bubbonica è una malattia zoonotica, così come la salmonellosi, la febbre bottonosa delle montagne rocciose e la malattia di Lyme.
Il fattore che più contribuisce all'aumento delle nuove zoonosi è l'aumentato contatto tra gli esseri umani e le forme di vita selvatiche. Questo può essere causato sia dallo spostamento di attività umana in zone selvagge sia dal movimento di animali selvatici in aree umane in seguito a disturbi antropologici o ambientali. Un esempio è la comparsa del Nipah virus in Malesia nel 1999, quando l'allevamento intensivo di suini fu introdotto nell'habitat naturale di pipistrelli fruttivori, portatori del virus. Cause non ancora chiarite determinarono il passaggio della patologia alla popolazione suina, che svolse un ruolo di ospite amplificatore e trasmise il virus ad alcuni allevatori, provocando la morte di 105 persone.
Un evento simile si è verificato in tempi più recenti, quando l'influenza aviaria ed il West Nile virus vennero trasmessi alla popolazione umana, probabilmente a causa delle interazioni tra gli ospiti portatori e gli animali domestici. Animali caratterizzati da grande mobilità, come pipistrelli e uccelli, possono determinare un rischio molto più alto di trasmissione di patologie zoonotiche, grazie alla facilità con la quale si possono spostare all'interno di aree abitate dall'uomo. Patologie come la malaria, la schistosomiasi, l'oncocercosi e l'elefantiasi non sono vere zoonosi, anche se possono essere trasmesse da insetti o utilizzare ospiti intermedi (vettore). Questo poiché necessitano, in almeno uno degli stadi di sviluppo, di un ospite umano.
Sorveglianza delle zoonosi
In Europa tutte le zoonosi sono sottoposte a un sistema di sorveglianza coordinata tra gli Stati membri. Secondo la Direttiva 2003/99/CE del Parlamento europeo e del Consiglio europeo del 17 novembre 2003 le zoonosi sono classificate in due categorie:
Zoonosi da sottoporre a sorveglianza
Sono tutte quelle riportate nel Regolamento di Polizia Veterinaria, tra cui:
- Brucellosi
- Campilobatteriosi
- Echinococcosi
- Listeriosi
- Salmonellosi
- Trichinellosi
- Tubercolosi causata da Mycobacterium bovis
- Infezioni da Escherichia coli produttori di verocitotossine
Zoonosi da sottoporre a sorveglianza in funzione della situazione epidemiologica
- Zoonosi virali (Calicivirus, Virus dell'epatite A, Virus dell'influenza, Virus della rabbia, Arbovirus)
- Zoonosi batteriche: (borreliosi, botulismo, leptospirosi, psittacosi, tubercolosi diverse da quella dovute a Mycobacterium bovis, vibriosi e yersiniosi)
- Zoonosi da parassiti: (anisakidosi, criptosporidiosi, cisticercosi e toxoplasmosi).
Lista di zoonosi
Note
Bibliografia
- Krauss, H., Zoonoses : infectious diseases transmissible from animals to humans, 3rd ed, ASM Press, 2003, ISBN 1-55581-236-8, OCLC 51647386.
- David Quammen, Spillover. L'evoluzione delle pandemie, Milano, Adelphi, 2014, ISBN 9788845932045.
Voci correlate
- Panzoozia
Altri progetti
- Wikizionario contiene il lemma di dizionario «zoonosi»
- Wikimedia Commons contiene immagini o altri file su zoonosi
Collegamenti esterni
- zoonosi, in Dizionario di medicina, Istituto dell'Enciclopedia Italiana, 2010.
- (EN) Millicent Eidson, zoonotic disease, su Enciclopedia Britannica, Encyclopædia Britannica, Inc.
- Zoonoses, su medical-microbiology.de.